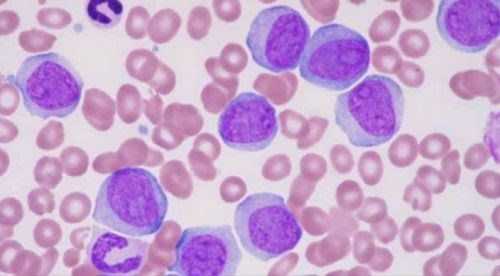

Hoạt động tư vấn, phản biện và giám định xã hội có đóng góp tích cực trong xây dựng chính sách
- Tháng mười hai 1, 2021
- By:Nguyễn Năng Tiến
- Category:Tin tức
- 0 comment
Hoạt động tư vấn, phản biện và giám định xã hội của Liên hiệp Hội Việt Nam đã đóng góp tích cực vào việc xây dựng đường lối, chủ trương, chính sách, pháp luật, Sáng nay (30/11), Liên hiệp các Hội Khoa học và Kỹ thuật Việt Nam (VUSTA) đã tổ chức hội thảo Tổng kết hoạt động tư vấn, phản biện và giám…